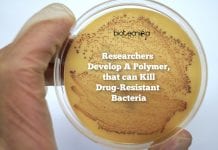
Polymer-Kills-Resistant-Bacteria

✅ 10 criteria passed
❌ 1 criteria to solve
Boost biotecnika.org's SEO with Kontactr's Guest Posting.
Secure high-authority, do-follow backlinks from our trusted site—DA44 domain authority and PA55 homepage and blog pages.
Perfect for webmasters seeking higher search rankings and increased organic traffic.
Simple, quick, and effective.
opens a new window
BioTecNika – Helps You Make Career in BioSciences Industry
https://biotecnika.org
BioTecNika is your news, jobs and opportunities website. We provide with the latest breaking news and videos straight from the Biotech industry. Come, Dive in.
https://biotecnika.org
BioTecNika – Helps You Make Career in BioSciences Industry
BioTecNika is your news, jobs and opportunities website. We provide with the latest breaking news and videos straight from the Bio...
Great, a redirect is in place to redirect traffic from your non-preferred domain. All versions of your page point to the same URL.
| Attribute | Value |
| ⓘ viewport | width=device-width, initial-scale=1.0 |
| ⓘ robots | max-snippet:-1, max-image-preview:large, max-video-preview:-1 |
ⓘ The results of our semantic analysis are shown below using the website's language.
They are the main concepts covered by biotecnika.org.
Each concept has a confidence score. The higher it is, the more important the topic is relative to the page.
| Topics | |
Biotechnology Confidence: 68% 
|
|
Employment Confidence: 66% 
|
|
Breaking news Confidence: 66% 
|
|
Industry Confidence: 64% 
|

ⓘ This website is ranked #43.842 by Alexa.
This rank is traffic based. The lower the rank is, the better the domain is ranked.
| Country | Rank |
 India India |
#4.391 |
 Ethiopia Ethiopia |
#3.065 |
Mobile Rendering
This website seems to be optimized for Mobile Visitors.
Phone
Tablet
A good text to HTML ratio is anywhere from 25 to 70%.
This percentage refers to the visible text ratio, as opposed to HTML elements, image tags and other non-visible information.
Great, we found headings on this page.
| Top level heading |
| Biotecnika |
For a better readability, only the first 20 <H3> tags are shown below.
| 3rd level heading |
| Superbug resistant plastic wraps developed by scientists (3) |
| Researchers develop polymer that can kill drug-resistant bacteria (3) |
| Scientists propose a new model for the matrix shell of hıv-1 (3) |
| Csır net dec 2019 question paper analysis & feedback from aspirants (3) |
| Csır ugc net december 2019 exam postponed in assam & meghalaya (3) |
| Lab training & ınternships |
| Crıspr training courses |
| Dbt biotech entrance exam courses |
| Gate biotech & life sciences courses |
| Csır net exam coaching courses |
| Most accepted gmo’s till date |
| Alice zhang – from princeton to verge genomics and forbes |
| How bacteria rule over your body – the microbiome |
| Overpopulation – the human explosion explained |
| Why meat ıs the best worst thing ın the world! |
| Breaking news: women scientist fellowship hiked (2) |
| Top 10 ınternational biotech scholarships you must apply for! (2) |
| Top 10 ethical dilemmas of 21st century scientists – a must… |
| ıs good cgpa in college enough to get jobs in biotech… |
| Top 10 phd research topics you can take up in 2019 |
| 4th level heading |
| News |
| Jobs |
| Don't mıss |
| Exam alerts |
| Scholarships |
| Latest on biotecnika |
| Biotecnika magazine |
| Biotecnika tv |
| Bt business news |
| Latest artıcles |
We found 170 images on this website.
32
ALT attributes are missing on your image tags. The issue affects 19 actual different images that could be loaded more than once in your page.
Alternative text allows you to add a description to an image.
Google rely on alternative text attributes to determine relevance to a search query. Alternative text also makes an image more likely to appear in a Google image search.
It looks like you're missing alternative text for 32 images on biotecnika.org. Check your website to make sure it's specified for each image on the page.
For a better readability, only the first 50 internal links are shown below.
| Anchor | Type | URL |
| No anchor | empty | https://www.facebook.com/biotecnika/?ref=nf |
| No anchor | empty | https://www.linkedin.com/company/biotecnika |
| No anchor | empty | https://www.twitter.com/biotecnika |
| No anchor | empty | https://vimeo.com/biotecnika |
| No anchor | empty | https://youtube.com/user/biotecnika |
| Like | text | https://www.facebook.com/biotecnika |
| Follow | text | https://twitter.com/biotecnika |
| Subscribe | text | https://www.youtube.com/biotecnika |
|
image | https://btnk.org/btn-10dec |
| ⓘ Domain Registrar | PDR LTD. D/B/A PUBLICDOMAINREGISTRY.COM |
| ⓘ Registration Date | 05/09/2007 18 years, 10 months, 13 days ago |
| ⓘ Last Modified | 04/01/2017 8 years, 11 months, 20 days ago |
| Host | IP Address | Country |
| tom.ns.cloudflare.com | 2606:4700:58::adf5:3b93 |  United States United States |
| eva.ns.cloudflare.com | 2400:cb00:2049:1::adf5:3a72 |  United States United States |




SOCIAL MEDIA PRESENCE
You have a relatively high presence on social media, keep going!
The more people share your website, the more likely you will get links from others, which is a key point when it comes to improving your overall search engine rankings.